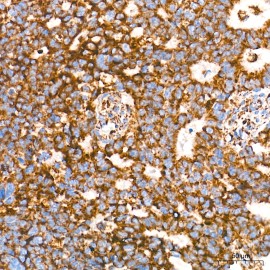
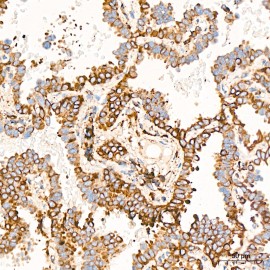
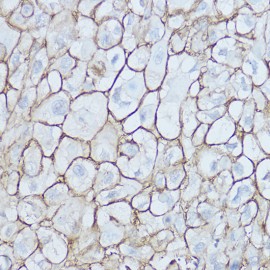
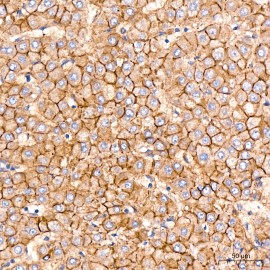
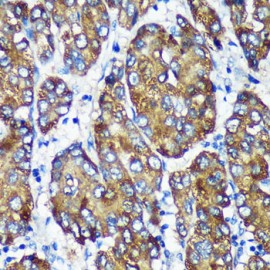
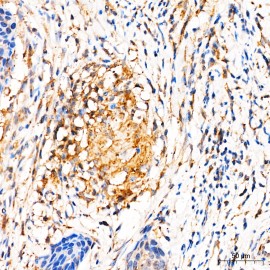
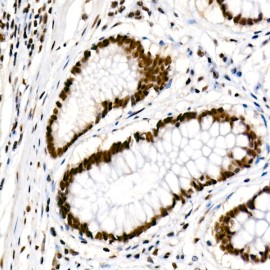

FadeStop™ Fluorescent Mounting Medium with DAPI (25 ml)
Your shopping cart is empty!
Product Description
FadeStop™ Fluorescent Mounting Medium is specially formulated to prolong the intensity of the fluorescence used in immunocytochemical and immunohistochemical staining. Our products can keep the fluorescent dyes from photobleaching for at least two months if the slides are stored at -20°C.
Key Features
• Retains excellent signals even after 12th laser scanning.
• Inhibits photobleaching for at least 4 months at -20°C.
• Ready-to-use and easy to use.
• Available with or without DAPI counterstain.
Component
1. FadeStop™ Fluorescent Mounting Medium with DAPI: 25 ml
Storage
Store at 4°C and protect from light.
Case Study

Left Figure: Hela cells were stained with CTCF antibody and mounted in FadeStop™ fluorescent mounting medium containing DAPI. The slide was stored at -20°C for 1 month before imaging using a Zeiss LSM 880 confocal laser scanning microscope. A series of scans were performed to assess the photobleaching speed of the fluorescent dye. Note that FadeStopTM fluorescent mounting medium effectively protected the fluorescence. Even after the 12th scan, the image quality remained high.
Right Figure: Hela cells were stained with CTCF antibody and mounted in FadeStop™ fluorescent mounting medium containing DAPI. Images were taken 1 day, 2 months, and 4 months after immunofluorescent staining using a Zeiss LSM 880 confocal laser scanning microscope. Nuclei were stained blue with DAPI. ACTB was stained magenta with Alexa Fluor 647. Scale bars: 20 μm.
Publications
1. Preserving Endothelial Integrity in Human Saphenous Veins during Preparation for Coronary Bypass Surgery.
Publication: JVR Product: FadeStop™ fluorescent mounting reagent with DAPI
Customer Testimonials
"I used anti-fade fluorescent mounting medium in immunocytochemistry and immunohistochemistry for over 7 years. Compared to other brands, FadeStop™ Mounting Medium stands out so well. It not only preserved the fluorescence of my samples when I used laser-scanning confocal microscopy, but it also gave me convenience by prolonging the fluorescence after staining. So now I can take my time by storing my slides in -20°C for a long period of time without having to take images immediately after staining."
""I tried FadeStop Fluorescent™ Mounting Medium with DAPI on fixed samples of Hydra vulgaris. The DAPI staining was bright and fast and the mounting medium effectively preserved fluorescent phalloidin stain. Thank you for an excellent product!""